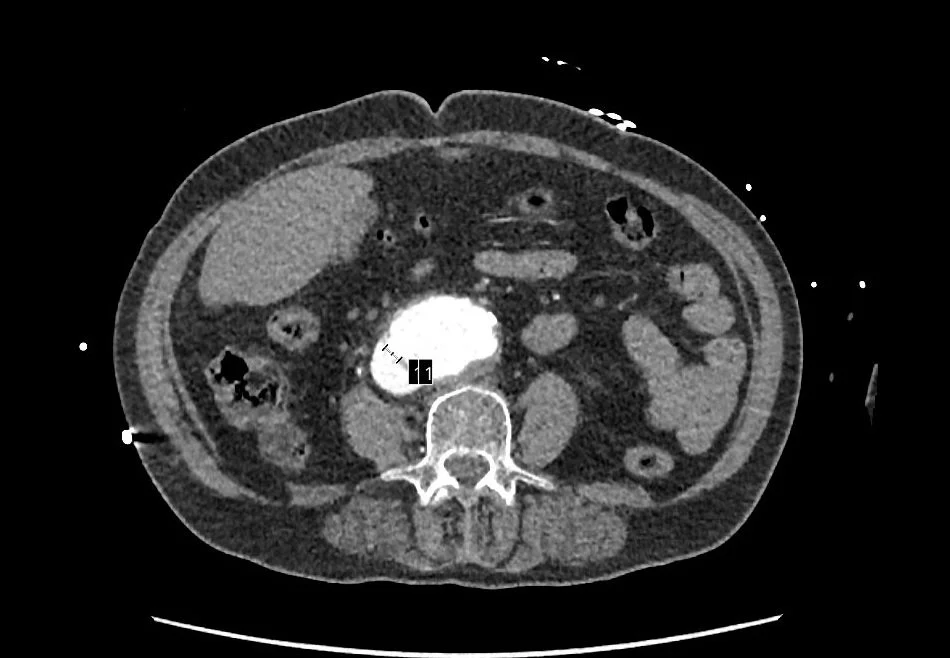
Aortocaval fistula (1).jpg

Extreme case leaves lasting memory
Lutheran’s Observation Unit is orderly. Busy, but controlled. A predictable flow carries a steady stream of patients, already on the mend, into Obs for a final check on their way out the door. Surprises are rare.
That’s what makes them memorable. That, and in this particular case, the rapid response team that had ruptured the familiar low-grade hum in Obs to attend to a woman who was “writhing in pain and hysterical,” whose blood pressure was plummeting.
And all of it was happening at shift change, when Adam Sheperdigian, MD, was arriving for work.
“To say she was ‘agitated’ is an understatement. Really, she was inconsolable,” he said. “It was an odd presentation. The pain, the hypotension, an abdomen that was tender and firm, and her CT, taken a few hours before, showed nothing concerning.”
But in this moment, everything was concerning. Sheperdigian ordered a CT with a full aortic component and started rolling her to the ICU. The patient clamped down, became muddled. She temporarily stabilized with a blood transfusion. Then, she went into shock.
Sheperdigian says a consult and surgery with Franco Rea, MD, saved her life. The culprit, illuminated by the CT Sheperdigian ordered and shown below: an aortocaval fistula.
An ACF is a rare, life-threatening complication in which an abdominal aortic aneurysm erodes into the adjacent inferior vena cava, causing a direct, high-pressure shunt between the two vessels. Immediate surgery is required, as untreated cases have a near 100-percent mortality rate, according to NIH.
But not today. This patient’s life-threatening condition was corrected with life-saving surgery. She was discharged and walked out of the hospital within days.
“It was a miraculous outcome. To be honest, it could not have gone any better,” Sheperdigian said. “Franco did all the hard work, and the nurses were fantastic.”
The tsunami of activity that swelled to meet the critical needs of this patient had passed, and Obs returned to the steady, rolling tide of its busy normal. All that remained from the moment was the memory of it.
“I’d heard about a case like this once before but I’d never seen it in action. It’s an important case to talk about,” he said. “Our strength as physicians comes from experience and exposure, and it’s empowering to know that a case like this is treatable.”
Our thanks to everyone involved in the care of this patient and all patients who require acute care at Lutheran every day.
Have an unusual or inspiring case you’d like to share with colleagues? Click here and we’ll reach out to you for the details.